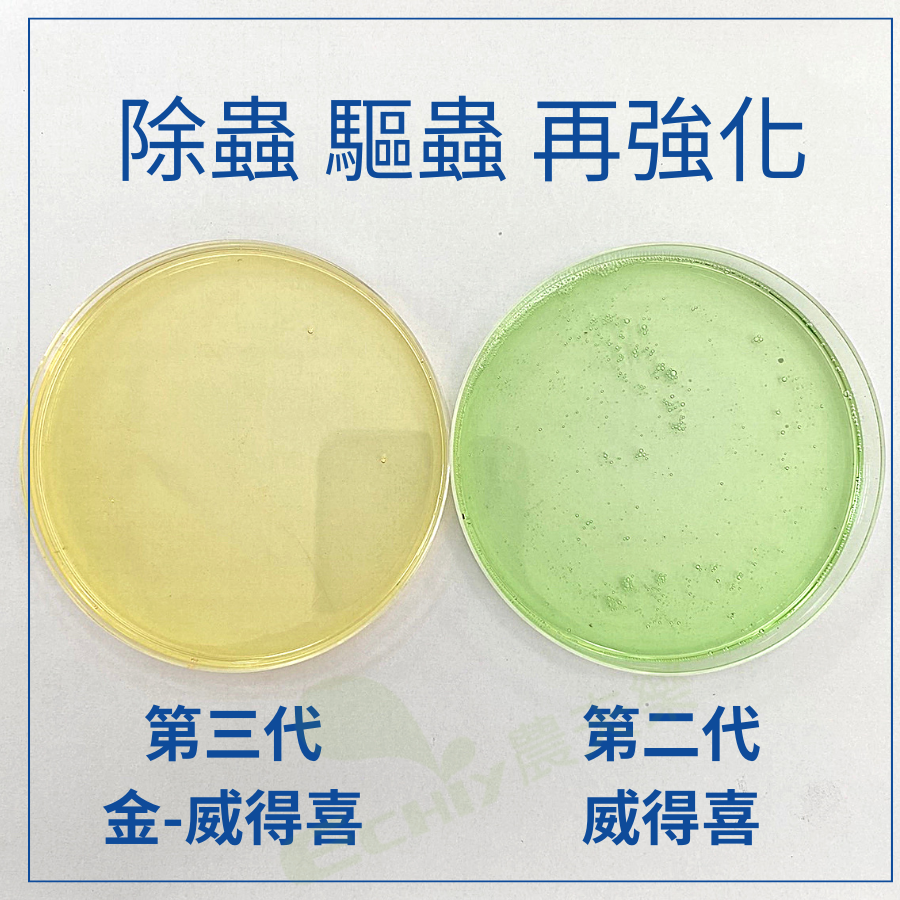

金威得喜 產品特色
提升天然酚類化合物濃度(如萜烯、多酚類(如類黃酮)、含氮化合物(如植物鹼、氰苷)等)
萜烯化合物,具有特殊氣味揮發性,對哺乳動物或昆蟲具拒食性
多酚類,可誘導植物產生抗病物質,抵禦病害入侵與擴散,增加昆蟲避食性
含氮化合物,植物鹼、氰苷類化合物都歸內在此,具刺激性氣味,植物鹼具有阻斷蛋白合成及運送;氰苷本身無毒性,但昆蟲攝取後水解會產生有毒氣體
【應用範圍】
所有花卉、蔬菜、雜糧及果樹均可使用
【使用方法】
單劑使用金-威得喜時,可稀釋200~500倍使用
搭配化學藥劑時,請稀釋800~1000倍使用,可增強藥效
【登記字號】: 植保製字第00129號
【商品名稱】: PREV-AM金-威得喜
【商品成分】: 柑橘精油、水
【成品性狀】: 液態
【包裝容量】: 1、3公升
【製造產地】: 美國
【有效期限】: 三年
物流說明


配送方式

- 小7:9公斤,全家:6公斤
- 包裝限制:45*30*30cm
- 便利商店僅服務註冊會員
- 配送約3~4日

- 可寄送總重量大於20公斤
- 無寄送偏遠山區及離島地區
- 偏遠地區定義:沒在你家附近出現過
- 配送約1~3日(不含例假)

- 單件重量不超過20公斤
- 包裹總長不可超過150公分
- 無寄送離島地區
- 配送約1~3日(不含例假)

- 單件重量不超過19.5公斤
- 包裹總長不可超過150公分
- 無寄送離島地區
- 可指定配送時間
- 配送約1~3日(不含例假)

- 單件重量不超過19.5公斤
- 包裹總長不可超過150公分
- 可寄送偏遠山區及離島地區
- 配送約1~3日(不含例假)

- 港、澳會員(專用物流)
- 匯款後貨到付運費
- 送時間約為7日內(不含例假)
付款與配送
| 轉帳匯款物流直送 | 貨到付款 | 網路信用卡刷卡 | |
![]() |
|||
![]() |
|||
![]() |
|||
![]() |

必看
調皮、淘氣的客人
- 吃飽飯來逛街的
- 自取"必看"沒看的
- 打破砂鍋問到底的
- 愛亂殺價的
- 臨時自取,門口狂按電鈴的
- 拿出鐵青的千元大鈔要找零的
- 隱瞞身分來探路的
- 2026目前頑皮人數:1
有閱讀自取的好康
- 幾乎不收尾數零頭
- 亂送消費者用的到產品
- 如倉庫有即期品任君免費挑一種
- 以上好康前題是前天沒跟老婆吵架
相關商品



















